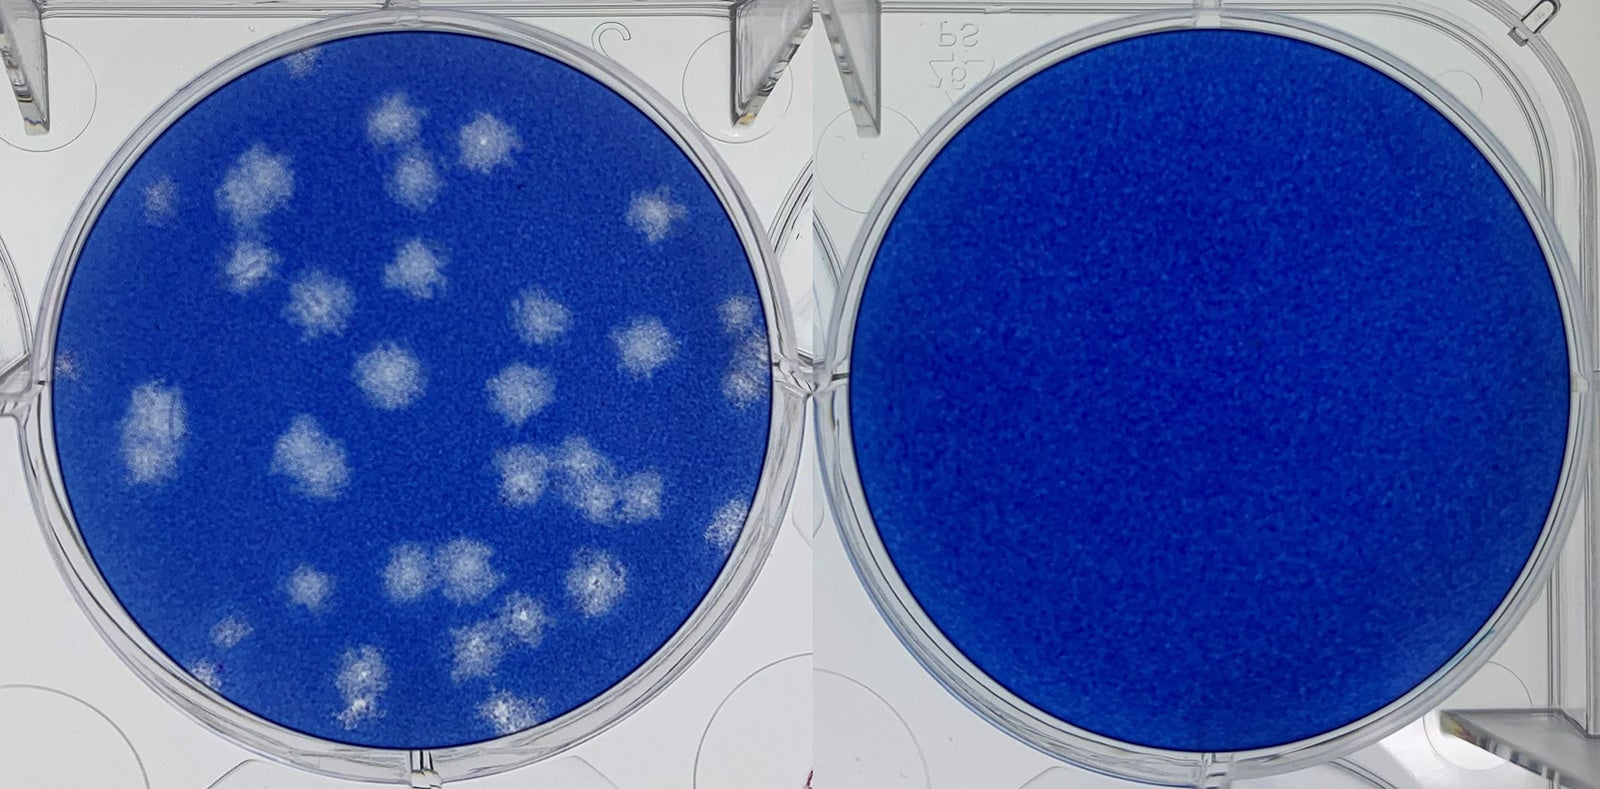
プラーク写真

世界初 約6畳(24立方メートル)の試験空間における付着新型コロナウイルスへの 「帯電微粒子水(ナノイー)」技術の抑制効果を検証
プラーク写真
プラーク写真
スパイクタンパク質のアミノ酸が変異し、細胞との結合力が増強したり、中和抗体との結合が起こりにくくなるなど感染性や伝播性、抗原性が変化した新たな変異株の発生により、依然として新型コロナウイルスによる世界的な感染拡大は収まる気配を見せません。現在、主流となっているオミクロン株の性状については研究段階ですが、家庭内での二次感染が増加するなど従来株に比べて感染力の増大が示唆されており、一層の感染予防対策が重要になっています。
当社は、「帯電微粒子水」技術について、2020年7月に新型コロナウイルス(SARS-CoV-2)に対する抑制効果(※2)、2021年11月には新型コロナウイルス変異株4種に対する抑制効果(※3)を実証しています。しかし、これまでの検証は45 Lという小さな試験空間で実施した結果であるため、大空間での効果については推測の域に留まっていました。
そこで今回は、約6畳(24立方メートル)の試験空間で「帯電微粒子水」の曝露有無によるウイルス感染価の比較実験を実施。ガーゼに付着させた新型コロナウイルス デルタ株に対して8時間「帯電微粒子水」を曝露した結果、99%以上の抑制効果を確認しました。なお、今回の検証は密閉された試験空間での結果であり、実使用空間における効果を検証したものではありません。
パナソニックは、今後も「帯電微粒子水」技術の可能性を追求するとともに、安心安全な空間を提供し、社会に貢献していきます。
※1 イオン放出式の空気浄化技術において(2022年3月1日現在、パナソニック調べ)
※2 帯電微粒子水の新型コロナウイルス(SARS-CoV-2)に対する抑制効果を確認(2020年7月リリース)
※3 新型コロナウイルスの懸念される変異株4種に対する「帯電微粒子水(ナノイー)」技術の抑制効果を検証(2021年11月リリース)
新型コロナウイルスと変異株4種のウイルス感染価には、株の違いによらず同じ減少傾向が認められたことから、「『帯電微粒子水』技術は一部のアミノ酸置換によるウイルス変異では不活化効果に影響を及ぼさず、今後も出現するであろう変異株に対しても45 Lの同条件下で試験を行えば、同様の結果が期待できる」という専門家の見解を得ています
全文は以下プレスリリースをご覧ください。
▼[プレスリリース] 世界初 約6畳(24立方メートル)の試験空間における付着新型コロナウイルスへの 「帯電微粒子水(ナノイー)」技術の抑制効果を検証(2022年3月1日)
https://news.panasonic.com/jp/press/data/2022/03/jn220301-3/jn220301-3.html
<関連情報>
・本検証結果の説明動画
https://www.youtube.com/embed/MKcvhiwkbak
すべての画像
